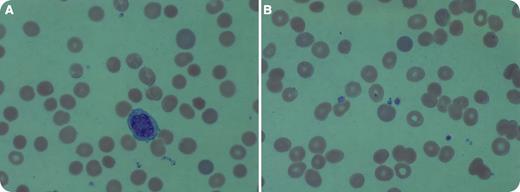
A 74-year-old nonsplenectomized male who had cutaneous squamous cell carcinoma of the scalp with locoregional metastases presented to the emergency room for altered mental status. He had completed metastasectomy and chemoradiation 2 months earlier. Imaging studies revealed no evidence of disease. On admission, he was weak and disoriented and had diarrhea. Complete blood count revealed mild anemia (hemoglobin 11 g/dL) and thrombocytopenia (platelet count 54 × 109/L). His platelets had been normal 3 weeks earlier. Reticulocyte count was 5.56% (0.5% to 2.17% normal range), haptoglobin was <15 mg/dL, and lactate dehydrogenase 540 IU/L (98 to 192 IU/L normal range), consistent with hemolysis. Peripheral blood smear showed moderate anisocytosis, poikilocytosis, polychromasia, and many intra- and extra-erythrocyte parasites, morphologically consistent with babesiosis (panels A and B). The patient’s wife recalled that he had walked in country grass a few weeks before his symptoms started. / Babesia microti can cause hemolytic anemia and thrombocytopenia. The illness usually persists for 2 weeks but fatigue may last longer. Immunosuppressed patients and patients older than age 50 years are more susceptible to this infection, as is the case with our patient. This case underscores the importance of carefully evaluating peripheral blood smear in any patient who presents with cytopenias. His mental status, anemia, and thrombocytopenia improved after antimicrobial treatment.

A 74-year-old nonsplenectomized male who had cutaneous squamous cell carcinoma of the scalp with locoregional metastases presented to the emergency room for altered mental status. He had completed metastasectomy and chemoradiation 2 months earlier. Imaging studies revealed no evidence of disease. On admission, he was weak and disoriented and had diarrhea. Complete blood count revealed mild anemia (hemoglobin 11 g/dL) and thrombocytopenia (platelet count 54 × 109/L). His platelets had been normal 3 weeks earlier. Reticulocyte count was 5.56% (0.5% to 2.17% normal range), haptoglobin was <15 mg/dL, and lactate dehydrogenase 540 IU/L (98 to 192 IU/L normal range), consistent with hemolysis. Peripheral blood smear showed moderate anisocytosis, poikilocytosis, polychromasia, and many intra- and extra-erythrocyte parasites, morphologically consistent with babesiosis (panels A and B). The patient’s wife recalled that he had walked in country grass a few weeks before his symptoms started.
Babesia microti can cause hemolytic anemia and thrombocytopenia. The illness usually persists for 2 weeks but fatigue may last longer. Immunosuppressed patients and patients older than age 50 years are more susceptible to this infection, as is the case with our patient. This case underscores the importance of carefully evaluating peripheral blood smear in any patient who presents with cytopenias. His mental status, anemia, and thrombocytopenia improved after antimicrobial treatment.
A 74-year-old nonsplenectomized male who had cutaneous squamous cell carcinoma of the scalp with locoregional metastases presented to the emergency room for altered mental status. He had completed metastasectomy and chemoradiation 2 months earlier. Imaging studies revealed no evidence of disease. On admission, he was weak and disoriented and had diarrhea. Complete blood count revealed mild anemia (hemoglobin 11 g/dL) and thrombocytopenia (platelet count 54 × 109/L). His platelets had been normal 3 weeks earlier. Reticulocyte count was 5.56% (0.5% to 2.17% normal range), haptoglobin was <15 mg/dL, and lactate dehydrogenase 540 IU/L (98 to 192 IU/L normal range), consistent with hemolysis. Peripheral blood smear showed moderate anisocytosis, poikilocytosis, polychromasia, and many intra- and extra-erythrocyte parasites, morphologically consistent with babesiosis (panels A and B). The patient’s wife recalled that he had walked in country grass a few weeks before his symptoms started.
Babesia microti can cause hemolytic anemia and thrombocytopenia. The illness usually persists for 2 weeks but fatigue may last longer. Immunosuppressed patients and patients older than age 50 years are more susceptible to this infection, as is the case with our patient. This case underscores the importance of carefully evaluating peripheral blood smear in any patient who presents with cytopenias. His mental status, anemia, and thrombocytopenia improved after antimicrobial treatment.
For additional images, visit the ASH IMAGE BANK, a reference and teaching tool that is continually updated with new atlas and case study images. For more information visit http://imagebank.hematology.org.